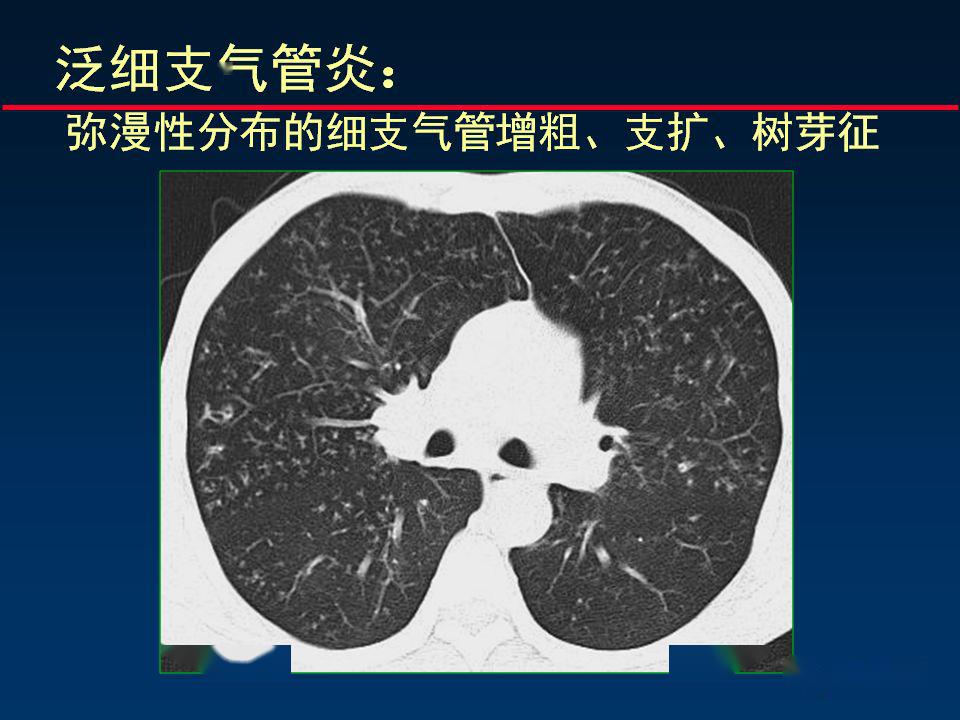
柳澄讲坛丨正确判读支气管异常的ct征象

支气管ct

2017年6月胸部ct提示双肺弥漫性小结节影,散在支气管扩张.
图片尺寸750x1086
ct表现:支气管壁增厚和气道扩张4,其他表现:长期患病或反复继发感染可
图片尺寸700x588
支气管轮廓异常和管壁增厚的ct表现
图片尺寸564x598
今日病例肺内支气管源性囊肿
图片尺寸1280x960
每天十张图,影像学习更简单!今天是支气管ct# - 抖音
图片尺寸1242x2208
支气管炎ct影像学表现为双肺纹理增粗,增多,纹理紊乱,双肺斑点状
图片尺寸1566x1280
经典图谱详细解说支气管扩张ct小诀窍
图片尺寸512x410
60岁,胸片示支气管炎治疗后复查ct.
图片尺寸800x688
支气管扩张的ct检查表现 - 医学知识与沟通交流 - 临药网 - powered
图片尺寸600x1362
柳澄讲坛丨正确判读支气管异常的ct征象
图片尺寸960x720
柳澄讲坛丨正确判读支气管异常的ct征象
图片尺寸960x720
肺ct不用死记硬背(三):视频解说"支气管解剖"
图片尺寸3024x4032
急性支气管炎一例
图片尺寸3264x2448
复查ct,患者原来狭窄闭塞的支气管已经复通.
图片尺寸2667x2000
支气管扩张?
图片尺寸640x480![精准判读支气管感染的基本ct表现 [病例帖]](https://i.ecywang.com/upload/1/img2.baidu.com/it/u=2878869095,29811899&fm=253&fmt=auto&app=138&f=JPEG?w=667&h=500)
精准判读支气管感染的基本ct表现 [病例帖]
图片尺寸960x720
经典图谱,详细解说支气管扩张ct小诀窍_腾讯新闻
图片尺寸640x506
无畏寒发热,无潮及盗汗,无胸痛,于我院急诊行胸部ct提示左肺支气管扩
图片尺寸2304x1728
【病例讨论】关于弥漫性泛细支气管炎的影像表现(补充资料再讨论)
图片尺寸2568x1652
"印戒征": 扩张支气管与ct扫描层面垂直时 (正常同级别的肺动脉
图片尺寸1080x810













![精准判读支气管感染的基本ct表现 [病例帖]](https://i.ecywang.com/upload/1/img2.baidu.com/it/u=2878869095,29811899&fm=253&fmt=auto&app=138&f=JPEG?w=667&h=500)

![精准判读支气管感染的基本ct表现 [病例帖]](https://img1.dxycdn.com/2020/0202/369/3394379114399322369-8w.jpg)


